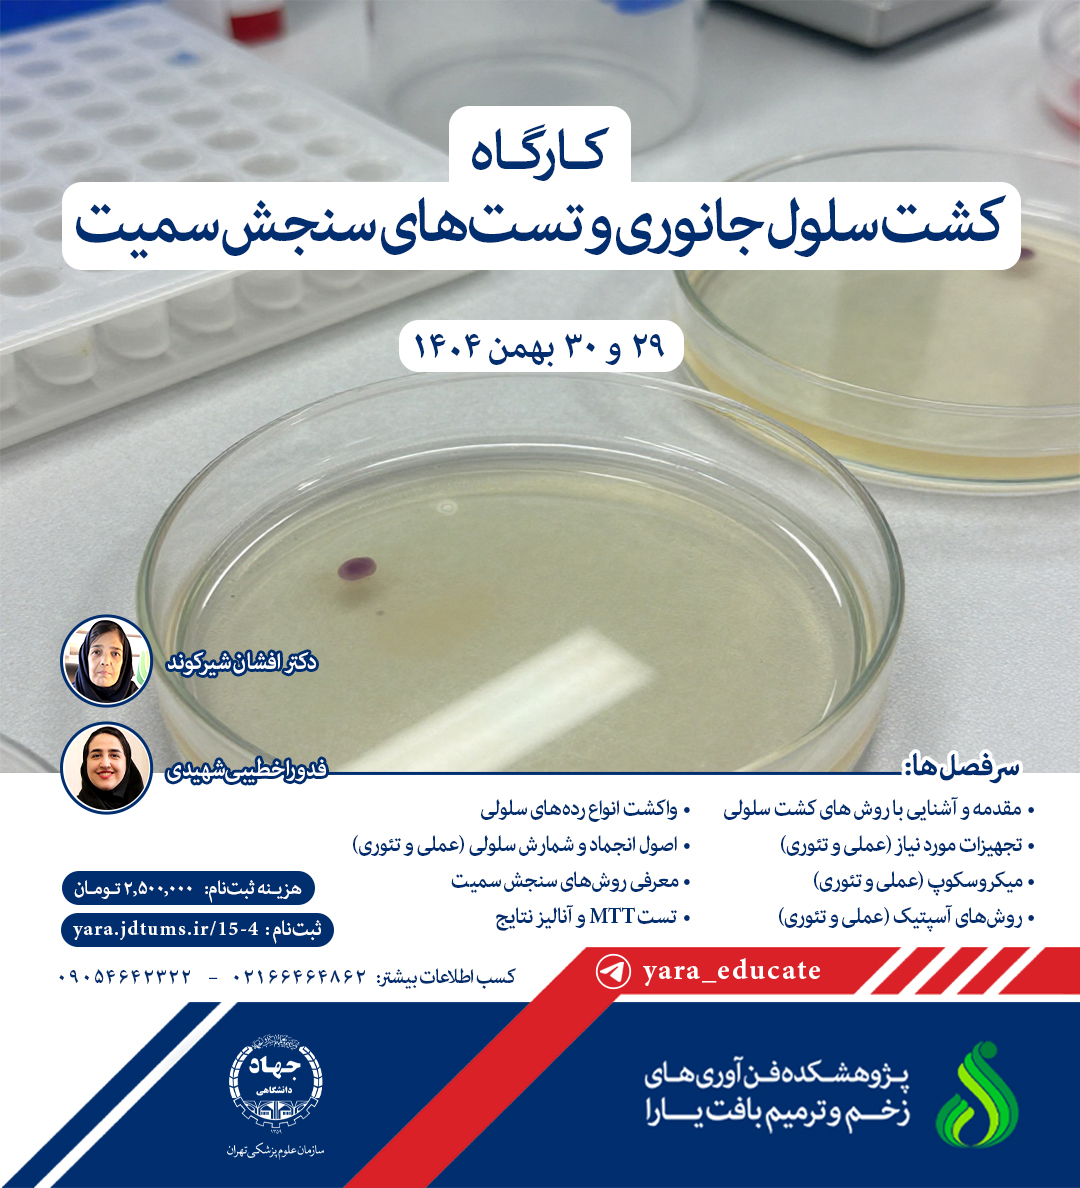
کارگاه کشت سلول جانوری و تست های سنجش سمیت

وبینار «غیرفعالسازی فوتونیکی» به مناسبت روز جهانی نور برگزار شد
۲۶ اردیبهشت ماه هرسال به عنوان روز جهانی نور، به پاس اهمیت نور و کاربردهای فناوریهای مبتنی بر آن در زندگی انسان، سلامت و علوم مختلف، در سراسر جهان گرامی داشته میشود. در این روز، برنامههای متنوعی از جمله سمینارها، کنگرهها، وبینارها و نمایشگاههایی با محوریت نور و فوتونیک برگزار ...